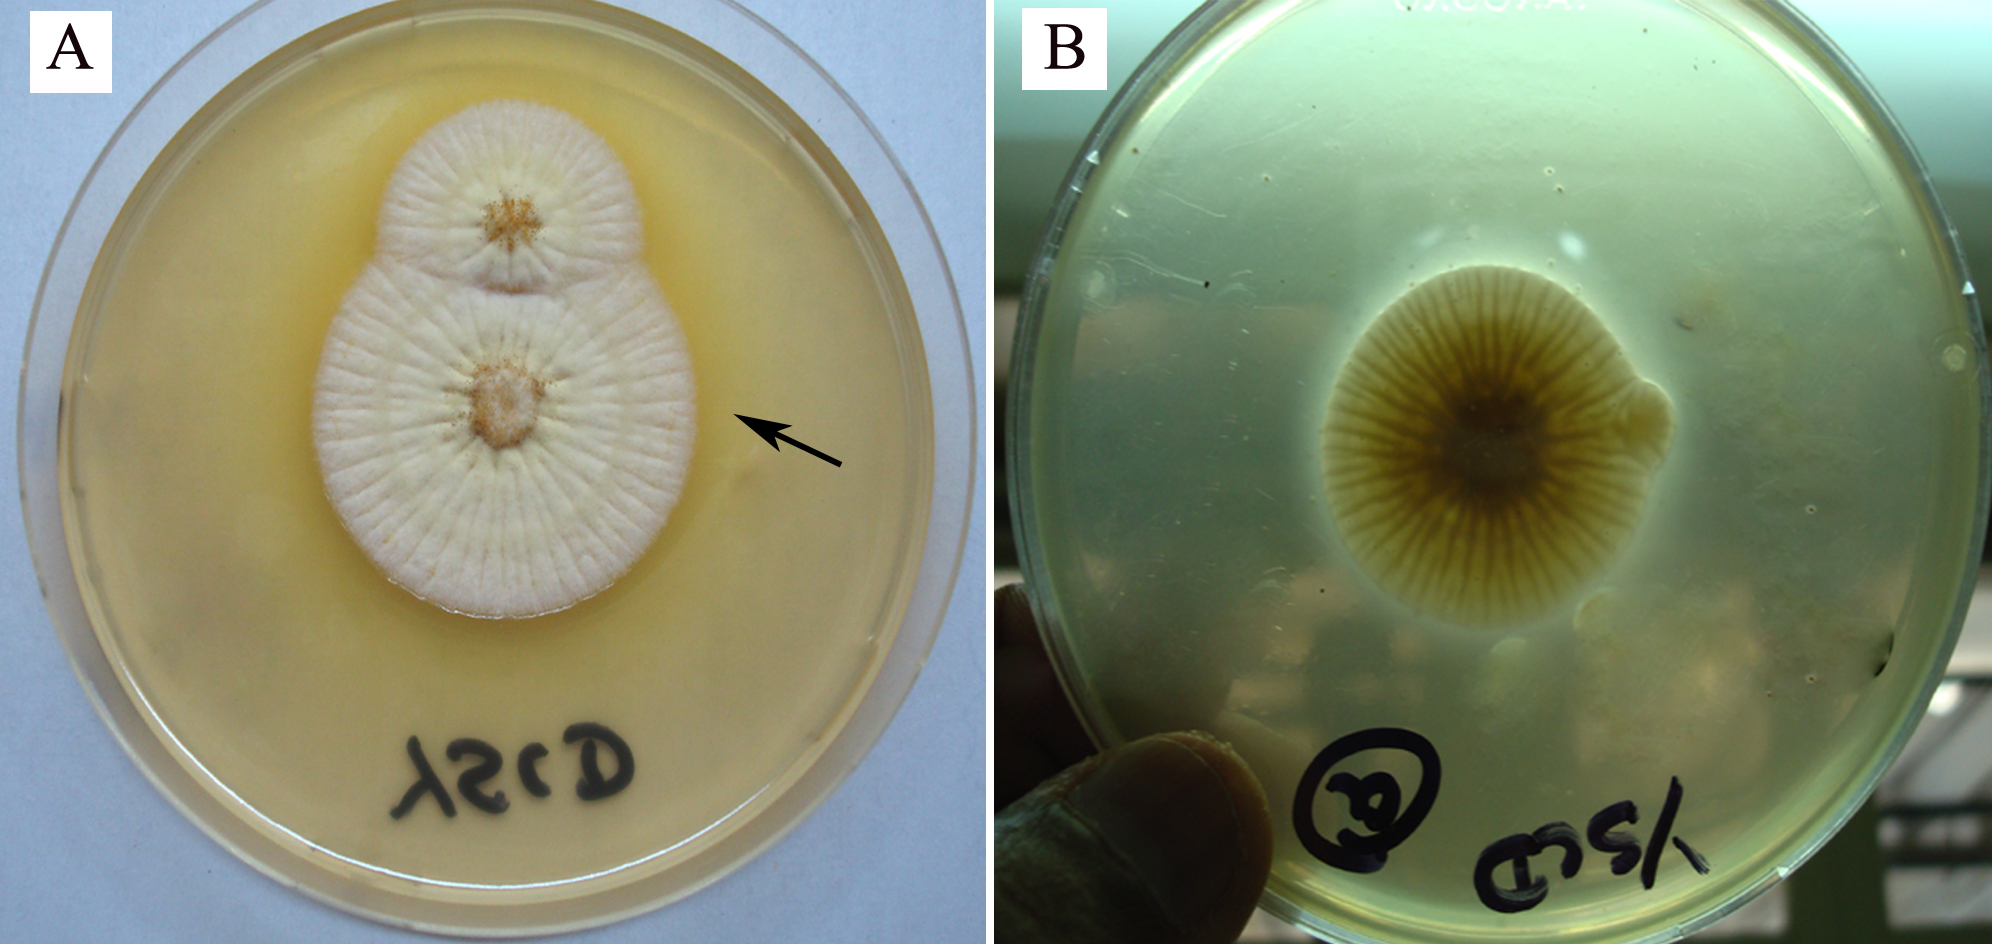

Figure 5. Three day-old growth of the
isolate of Aspergillus flavus on yeast extract sucrose agar
(supplemented with methyl β-cyclodextrin and sodium desoxycholate),
incubated at 30 °C. A: Three day-old growth of a clinical
isolate of Aspergillus flavus on yeast extract sucrose agar
(supplemented with methyl β-cyclodextrin and sodium desoxycholate),
incubated at 30 °C. A beige ring (arrow) has formed around the
colony. Formation of a beige ring was noted significantly more
frequently in aflatoxin-producing strains than in
aflatoxin-nonproducing strains. B: Three day-old growth of an
environmental isolate of Aspergillus flavus on yeast extract
sucrose agar supplemented with methyl β-cyclodextrin and sodium
desoxycholate), incubated at 30 °C. There is no beige ring around
the colony growth.